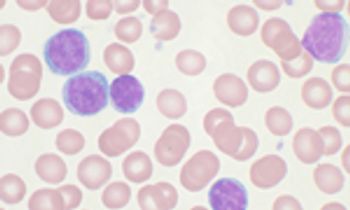

The immunotherapy DPX-Survivac has been granted orphan drug designation as treatment ovarian cancer, based on early-phase research showing a robust immune response with the therapy in combination with low-dose cyclophosphamide.

The immunotherapy DPX-Survivac has been granted orphan drug designation as treatment ovarian cancer, based on early-phase research showing a robust immune response with the therapy in combination with low-dose cyclophosphamide.

Takeda released a statement saying that a new drug application was submitted for ixazomib (MLN9708), an oral proteasome inhibitor, used in combination with lenalidomide and dexamethasone, as a treatment for patients with relapsed and/or refractory multiple myeloma.

The approval of necitumumab, combined with gemcitabine and cisplatin for the first-line treatment of patients who have locally advanced or metastatic squamous non-small cell lung cancer (NSCLC), was supported by FDA’s Oncologic Drugs Advisory Committee (ODAC).

Patients with heavily pretreated colorectal cancer who harbored genetic defects in mismatch repair experienced high response rates when treated with the programmed cell death protein-1 inhibitor pembrolizumab (Keytruda), according to findings from an ongoing phase II study.

Patients with pretreated advanced ovarian cancer demonstrated encouraging signs of antitumor activity with monoclonal antibodies against programmed death-1 and its ligand PD-L1, according to findings from two clinical studies presented at the 2015 ASCO Annual Meeting.

Marking the first time a phase III study has shown a survival advantage for patients with soft tissue sarcoma, treatment with eribulin (Halaven) demonstrated improved overall survival (OS) by 2 months compared with dacarbazine in patients with advanced leiomyosarcoma (LMS) and adipocytic sarcoma (ADI).

Monotherapy with daratumumab demonstrated promising overall survival and objective response rates in patients with double-refractory multiple myeloma.

MPDL3280A reduced the risk of death by 53% compared with docetaxel in previously treated patients with PD-L1-positive squamous and non-squamous non-small cell lung cancer.

Enzalutamide significantly improved progression-free survival and PSA progression compared with bicalutamide in men with metastatic and non-metastatic castration-resistant prostate cancer.

Zarxio, the first FDA-approved biosimilar, has effectively been blocked from reaching US markets by an injunction from Amgen.

Topline findings from the phase III COMPLEMENT 2 study indicated that treatment with ofatumumab (Arzerra) plus fludarabine and cyclophosphamide significantly improved progression-free survival (PFS) compared with fludarabine and cyclophosphamide alone in patients with relapsed chronic lymphocytic leukemia (CLL).

Following the FDA fast track designation in November 2014, Merrimack Pharmaceuticals and Baxter International have completed the submission of a new drug application for MM-398 in combination with 5-fluorouracil and leucovorin, according to a statement from the drug's developers.

The FDA has issued a label update for pomalidomide (Pomalyst) plus low-dose dexamethasone to include data from the phase III MM-003 study.

The FDA has approved second-line ramucirumab (Cyramza) in combination with FOLFIRI as a treatment for patients with metastatic colorectal cancer (mCRC) following progression on a first-line bevacizumab-containing regimen.

The PD-L1 inhibitor MPDL3280A demonstrated a 19% objective response rate (ORR) with 75% of responses ongoing in pretreated patients with metastatic triple-negative breast cancer (TNBC).

The FDA has granted a breakthrough therapy designation to the PARP1/2 inhibitor rucaparib for the treatment of women with BRCA-mutated advanced ovarian cancer.

The FDA has granted an accelerated approval to an oral suspension formulation of deferasirox (Jadenu) for the treatment of patients aged 2 and older with chronic iron overload due to multiple blood transfusions.

The FDA has updated the label for abiraterone acetate (Zytiga) plus prednisone to include data from the final analysis of the phase III COU-AA-302 study.
Combination therapy with ibrutinib plus bendamustine and rituximab significantly extended progression-free survival compared with BR alone in patients with chronic lymphocytic leukemia or small lymphocytic lymphoma enrolled in the phase III HELIOS trial.

Heterogeneity, which can result in treatment resistance, is commonly underestimated and misunderstood, representing an important area of future research.

While not appropriate for all patients with ER-positive breast cancer, neoadjuvant endocrine therapy could play an important role in select groups of women with comorbidities or those with ER-rich/luminal A disease.

Cytogenetic and molecular data are becoming increasingly important in the individualization of treatment of patients with acute myeloid leukemia (AML).

Dinutuximab (Unituxin) has been approved by the FDA in combination with interleukin-2, granulocyte-macrophage colony-stimulating factor (GM-CSF), and isotretinoin as a frontline therapy for pediatric patients with high-risk neuroblastoma.

Through a $21 billion acquisition of Pharmacyclics, AbbVie has announced plans to acquire the blockbuster BTK inhibitor ibrutinib (Imbruvica).

The FDA has approved panobinostat (Farydak) in combination with bortezomib (Velcade) and dexamethasone for patients with previously treated multiple myeloma.

Amgen and its subsidiary Onyx Pharmaceuticals have submitted an sNDA to the FDA for the full regulatory approval of carfilzomib (Kyprolis) as a treatment for patients with relapsed multiple myeloma.

The FDA has scheduled a hearing to discuss the biologics license application (BLA) for the immunotherapy talimogene laherparepvec (T-VEC) as a treatment for patients with metastatic melanoma.

Acting two months ahead of its deadline, the FDA granted an accelerated approval to palbociclib (Ibrance) as a first-line treatment for patients with ER-positive metastatic breast cancer.

The FDA has approved nivolumab (Opdivo) for patients with unresectable or metastatic melanoma following treatment with ipilimumab or a BRAF inhibitor, based on data from the phase III CheckMate-037 trial.

Fulvestrant (Faslodex) improved overall survival (OS) by 5.7 months compared with anastrozole as a frontline treatment for postmenopausal women with HR-positive metastatic breast cancer. These findings from the phase II FIRST trial were presented at the 2014 San Antonio Breast Cancer Symposium.